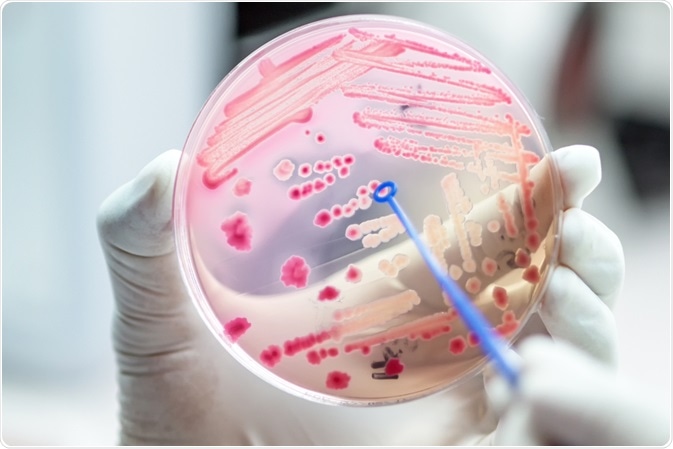
antimicrobial

Antimicrobials have revolutionized medical science during the 20th Century. The history of antimicrobial discovery has been a long and storied one, culminating in strides in the fight against human disease.
Antimicrobials have revolutionized medical science during the 20th Century. The history of antimicrobial discovery has been a long and storied one, culminating in strides in the fight against human disease.
Image Credit: AnaLysiSStudiO / Shutterstock.com
Image Credit: AnaLysiSStudiO / Shutterstock.com
Antimicrobials – An overview
There are 3 main classes of antimicrobials – disinfectants, antiseptics, and antibiotics. Disinfectants (which include bleach and common household cleaning materials) are non-selective agents that kill microbes on non-living surfaces, preventing their spread. Antiseptics are applied to living tissue during surgery, reducing microbial infection. Antibiotics are drugs that are used to destroy microbes within the body by either killing them or slowing their development and growth.
The term “antibiotics” is used to specifically refer to antibacterials but in recent years it has been expanded to include drugs that treat all forms of microbe. It also used to only describe drugs that were derived from living microorganisms but now includes synthetic formulations such as fluoroquinolones and sulfinamides. Antibacterial agents can be subdivided into bactericidal and bacteriostatic agents.
Since the late 19th/early 20th century, many antimicrobial drugs have been developed and released onto the market worldwide, treating a variety of infectious diseases. They are designed to kill or slow down the activity of microbes. They include antibacterials, antivirals, antifungals, and antiparasitic drugs.
Antimicrobials in the ancient world
Nowadays, most people assume that before the advent of the antimicrobial revolution in the latter half of the 20th-century people automatically succumbed to the effects of infectious disease with no protection against it. This is not so, however. There is a plethora of evidence that human societies have employed the use of antimicrobials for over 2000 years.
There were a variety of, albeit poorly understood, treatments available for victims of infectious disease. Herbs, honey, and even animal feces were used. Mortality rates were far higher in the ancient world, however.
Perhaps the most relevant and widespread use of an antimicrobial agent in ancient societies was the topical use of moldy bread as a therapeutic. There is documented evidence of its use in Egypt, Serbia, China, Greece, and the Roman Empire. The widespread use of molds in this manner has been documented in John Parkinson’s Theatrum Botanicum, published in 1640.
There is even archeological evidence of antibiotics that are used in the modern world in Nubia and Roman-occupied Egypt. Traces of tetracycline has been discovered in bones of human skeletons from these eras, although their origin remains a mystery.
The renaissance and enlightenment
The advent of modern antimicrobial discovery did not, however, gather pace until the 17th century, when Antonie Philips van Leeuwenhoek discovered bacteria with his microscope. After communicating his findings to Robert Hooke, a founding member of the Royal Society, this started the study of bacteriology.
In the late 1800s, Robert Koch and Louis Pasteur both established that there was an association between bacteria and disease via propagation in animals and on artificial media. This discovery had a far-reaching effect on modern medicine which lasts to this day.
During the last few centuries of the pre-antibiotic era, there was also experimentation with possible treatments which often had worse side-effects than the diseases themselves.
The spread of syphilis and gonorrhea, both common sexually transmitted infections at the time, prompted the application of such harmful heavy metals as bismuth, arsenic, and mercury. These were either administered systemically or locally by means of specially designed syringes.
The modern era of antimicrobial discovery
Arguably the first antibiotic which was used to treat infectious disease in humans was pyocyanase. Emmerich and Löw isolated green bacteria from bandages in the mid-19th century which inhibited the growth of other bacteria. The microorganism Pseudomonas aeruginosa was then employed as a medicine, albeit with mixed success.
The father of antimicrobial chemotherapy is Paul Ehrlich. He worked with other notable figures such as Robert Koch and Emil von Behring in the development of an improved diphtheria antitoxin, which became the basis for modern antibacterial therapies. This also led to the development of commonly used histological stains such as the Gram’s stain.
His work on Salvarsan, an arsenic-based chemical, in 1909, was probably the first truly modern antimicrobial agent.
Penicillin – A revolutionary medicine
Penicillin, when it was discovered and when it became widely available, gave medical professionals a powerful new tool that helped to kickstart a revolution in the fight against infectious disease. Even though Alexander Fleming is widely credited with its discovery in 1928, there were arguably others who got there before him. These include Sir John Scott Burdon-Sanderson and Joseph Lister in the 19th century.
However, there were issues with making penicillin commercially available in the early days. It was not until Florey and Chain published a paper in 1940 which described a purification technique that this progressed. In 1945, penicillin became available for limited use.
There were problems with this antibiotic that persist to this day, for example, it has a poor bioavailability. Around this time, sulfonamides were also being developed by scientists at Bayer in Germany.
The development of modern antimicrobial drugs
The “Golden Age” of antimicrobial discovery lasted 20 years from the mid-1940s to the 1960s. Initially, the main source of new drugs was from naturally occurring sources. The discovery and isolation of streptomycin in 1944 led to a worldwide search for sources of new antibiotics. In the 1950s Vancomycin was extracted from samples found in Borneo and sent back by Christian missionaries.
Since then, many different antimicrobials have been developed from both natural and synthetic sources. Methicillin was developed in 1959, and ampicillin was developed in 1961, both as solutions to increased antibiotic resistance. Cephalosporins emerged in the 1960s, which led to the development of ceftazidime in the late 1970s.
The problem of antibiotic resistance, which was first identified in the 1950s, has led to new ways of thinking in the field of antimicrobial development. The development of resistance has outstripped the ability to develop drugs that can combat strains of resistant bacteria.
Undoubtedly, the future development of antimicrobial drugs will depend upon drug discovery and the smart applications of technologies such as genetic engineering and other scientific fields to the field of antimicrobial development.
Sources
Bassett, E.J. et al (1980) Tetracycline-labeled human bone from ancient Sudanese Nubia (A.D. 350) Science 209 (4464) pp. 1532-1534 [Accessed Online 12th November 2020] https://science.sciencemag.org/content/209/4464/1532.abstract
Levine, D.P. (2006) Vancomycin: A History Clinical Infectious Diseases 42 (1) pp. S-5-S12 [Accessed Online 12th November 2020] https://doi.org/10.1086/491709
Russell, A.D. (1975) The antibacterial activity of a new cephalosporin, cefamandole Journal of Antimicrobial Chemotherapy 1 (1) pp. 97-101 [Accessed Online 12th November 2020] https://doi.org/10.1093/jac/1.1.97
Aminov, R.I. (2010) A brief history of the antibiotic era: lessons learned and challenges for the future Front. Microbiol. 8/12/2010 [Accessed Online 12th November 2020] https://www.frontiersin.org/articles/10.3389/fmicb.2010.00134/full
Further Reading
Last Updated: Nov 16, 2021